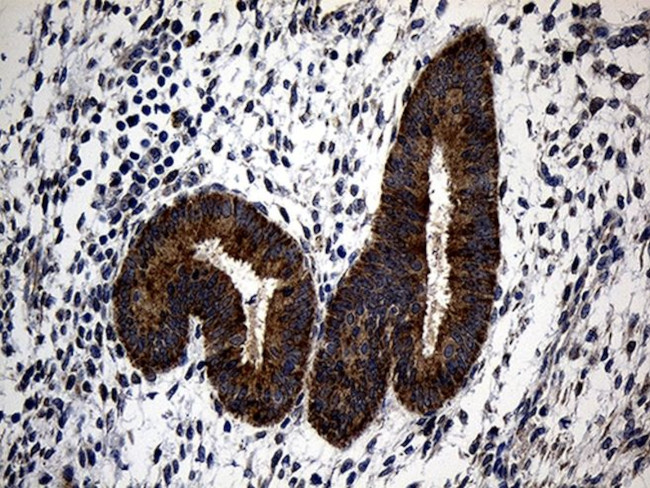
ALDH7A1 Antibody in Immunohistochemistry (Paraffin) (IHC (P))

Search
OriGene
ALDH7A1 Monoclonal Antibody (OTI10A12), TrueMAB™
{{$productOrderCtrl.translations['antibody.pdp.commerceCard.promotion.promotions']}}
{{$productOrderCtrl.translations['antibody.pdp.commerceCard.promotion.viewpromo']}}
{{$productOrderCtrl.translations['antibody.pdp.commerceCard.promotion.promocode']}}: {{promo.promoCode}} {{promo.promoTitle}} {{promo.promoDescription}}. {{$productOrderCtrl.translations['antibody.pdp.commerceCard.promotion.learnmore']}}
图: 1 / 5
ALDH7A1 Antibody (CF811150) in IHC (P)





产品信息
CF811150
种属反应
宿主/亚型
分类
类型
克隆号
抗原
偶联物
形式
浓度
规格
纯化类型
保存液
内含物
保存条件
运输条件
产品详细信息
For reconstitution, we recommend adding 100 µL distilled water to a final antibody concentration of about 1 mg/mL. To use this carrier-free antibody for conjugation experiments, we strongly recommend performing another round of desalting. (Zeba Spin Desalting Columns, 7KMWCO, 0.5 mL, Product # 89882)
靶标信息
The protein encoded by this gene is a member of subfamily 7 in the aldehyde dehydrogenase gene family. These enzymes are thought to play a major role in the detoxification of aldehydes generated by alcohol metabolism and lipid peroxidation. This particular member has homology to a previously described protein from the green garden pea, the 26g pea turgor protein. It is also involved in lysine catabolism that is known to occur in the mitochondrial matrix. Recent reports show that this protein is found both in the cytosol and the mitochondria, and the two forms likely arise from the use of alternative translation initiation sites. An additional variant encoding a different isoform has also been found for this gene. Mutations in this gene are associated with pyridoxine-dependent epilepsy. Several related pseudogenes have also been identified.
仅用于科研。不用于诊断过程。未经明确授权不得转售。
篇参考文献 (0)
生物信息学
蛋白别名: 26g turgor protein homolog; aldehyde dehydrogenase 7 family, member A1; Aldehyde dehydrogenase family 7 member A1; aldehyde dehydrogenase family 7, member A1; Alpha-AASA dehydrogenase; Alpha-aminoadipic semialdehyde dehydrogenase; Antiquitin 1; Antiquitin-1; Antiquitin1; Betaine aldehyde dehydrogenase; Delta1-piperideine-6-carboxylate dehydrogenase; delta1-piperideine-6-carboxylate dehydrogenease; epididymis secretory sperm binding protein; P6c dehydrogenase; unnamed protein product
基因别名: Ald7a1; ALDH7A1; antiquitin; ATQ1; D18Wsu181e; EPD; EPEO4; PDE
UniProt ID: (Human) P49419, (Rat) Q64057, (Mouse) Q9DBF1
Entrez Gene ID: (Human) 501, (Rat) 291450, (Mouse) 110695